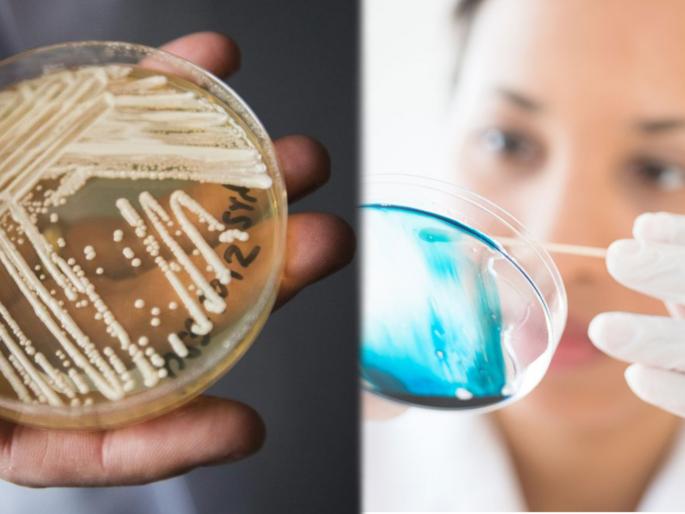
deadly fungus could cause pandemic more fatal than covid | संकटं संपता संपेना! कोरोनापेक्षाही खतरनाक फंगसने शास्त्रज्ञांच्या चिंतेत भर; माजवू शकतो हाहाकार deadly fungus could cause pandemic more fatal than covid | संकटं संपता संपेना! कोरोनापेक्षाही खतरनाक फंगसने शास्त्रज्ञांच्या चिंतेत भर; माजवू शकतो हाहाकार

संकटं संपता संपेना! कोरोनापेक्षाही खतरनाक फंगसने शास्त्रज्ञांच्या चिंतेत भर; माजवू शकतो हाहाकार
By ऑनलाइन लोकमत | Updated: February 2, 2021 12:07 IST2021-02-02T12:00:23+5:302021-02-02T12:07:33+5:30
Candida Auris : कोरोनाच्या संकटाचा सामना करत असतानाच आता कोरोनापेक्षाही जास्त खतरनाक व्हायरस असल्याची माहिती मिळत आहे.
संकटं संपता संपेना! कोरोनापेक्षाही खतरनाक फंगसने शास्त्रज्ञांच्या चिंतेत भर; माजवू शकतो हाहाकार
कोरोना व्हायरसने संपूर्ण जगाला विळखा घातला आहे. अनेक प्रगत देशही कोरोनापुढे हतबल झाले आहेत. रुग्णांची संख्या सातत्याने वाढत असल्याने काही ठिकाणी अत्यंत गंभीर परिस्थिती निर्माण झाली आहे. जगभरातील सर्वच देश कोरोनाचा सामना करत आहे. मात्र आता धडकी भरवणारी माहिती समोर आली आहे. कोरोनाच्या संकटाचा सामना करत असतानाच आता कोरोनापेक्षाही जास्त खतरनाक व्हायरस असल्याची माहिती मिळत आहे. एका फंगसने शास्त्रज्ञांची चिंता वाढवली असून तो धुमाकूळ घालू शकतो अशी शक्यता देखील वर्तवण्यात येत आहे.
"कँडिला ऑरिस" असं या फंगसचं नाव असून तो ब्लॅक प्लेगचा प्रसारामधून निर्माण होत आहे. हा फंगस अत्यंत धोकादायक असल्याचं म्हटलं जात आहे. शास्त्रज्ञांच्या मते कोरोना व्हायरसपेक्षाही मोठी महामारी आणण्यासाठी हा फंगस सक्षम आहे. त्यामुळेच "कँडिला ऑरिस" हा जास्त खतरनाक ठरत आहे. तसेच याचा प्रसार देखील वेगाने होत आहे. डिजीज कंट्रोल अँड प्रिव्हेंशन सेंटरच्या शास्त्रज्ञांनी दिलेल्या माहितीनुसार, कँडिला ऑरिस हा अधिक प्रभावी असल्याने त्यावर अँटीफंगल औषधांचा देखील परिणाम होत नसल्याचं पाहायला मिळत आहे.

जमिनीवर खूप वेळ जिवंत राहू शकतो "हा" फंगस
सीडीसीशी संबंधित शास्त्रज्ञांनी या फंगसचा प्रसार रुग्णालयात झाला तर तो खूपच जास्त धोकादायक होईल असं म्हटलं आहे. लंडन इम्पीरिअल कॉलेजमधील महामारी विशेषज्ञ जोहाना रोड्स यांनी "कँडिला ऑरिस" हा जमिनीवर खूप वेळ जिवंत राहू शकतो असं म्हटलं आहे. तसेच रोड्स 2016 मध्ये या फंगसमुळे निर्माण झालेल्या संक्रमणावर ताबा मिळवणाऱ्या टीममध्ये होत्या. तसेच माकडांमुळे याचा संसर्ग होत असल्याने त्याची ब्लॅक प्लेगसोबत तुलना होत असल्याचं देखील त्यांनी म्हटलं आहे. एका हिंदी वेबसाईटने याबाबतचे वृत्त दिले आहे.
CoronaVirus News : चीनची चाल? पोलिसांनी केलेल्या छापेमारीत तब्बल 3 हजारांहून अधिक बनावट डोस जप्त, लोकांमध्ये भीतीचे वातावरणhttps://t.co/o5zUpDzUrR#CoronaVirusUpdates#coronavirus#CoronaVaccine#China
— Lokmat (@MiLOKMAT) February 2, 2021
बापरे! बनावट लस पुरवठा करणाऱ्या टोळीचा पर्दाफाश, 3000 डोस जप्त; 80 जणांना अटक
कोरोनामुळे भीतीचे वातावरण निर्माण झालेले असतानाच आणखी एक धक्कादायक माहिती समोर आली आहे. चीनमध्ये बनावट लस पुरवठा करणारे रॅकेट उघडकीस आले आहे. बनावट लस पुरवठा करणाऱ्या टोळीचा पर्दाफाश झाला आहे. चीनच्या न्यूज एजन्सीने दिलेल्या माहितीनुसार, पोलिसांनी याप्रकरणी 80 हून अधिक जणांना अटक केली आहे. टोळीकडून तीन हजारांहून अधिक बनावट डोस जप्त करण्यात आले आहे. यामुळे तेथील नागरिकांची चिंता वाढली आहे. चीनी वृत्तसंस्था सिन्हुआने दिलेल्या वृत्तानुसार, या टोळीकडून गेल्या सप्टेंबर महिन्यांपासून बनावट लसीचा पुरवठा सुरू होता. पोलीस या बनावट लसीच्या मागावर होते. अखेर या टोळीपर्यंत पोहचण्यास पोलिसांना यश आलं. ग्लोबल टाइम्सने आपल्या एका रिपोर्टमध्ये या बनावट लसी परदेशातही पोहचवण्याचा या टोळीचा प्रयत्न असू शकतो अशी शक्यता व्यक्त केली आहे. पोलिसांनी बीजिंग, शांघाई, पूर्व प्रांतातील शानदोंगसह अनेक ठिकाणी छापेमारी केली.
कोरोनाच्या संकटात मास्क न वापरणं बेतलं जीवावर https://t.co/ARLilLzDJS#coronavirus#Corona#CoronaVirusUpdates#Mask
— Lokmat (@MiLOKMAT) January 30, 2021